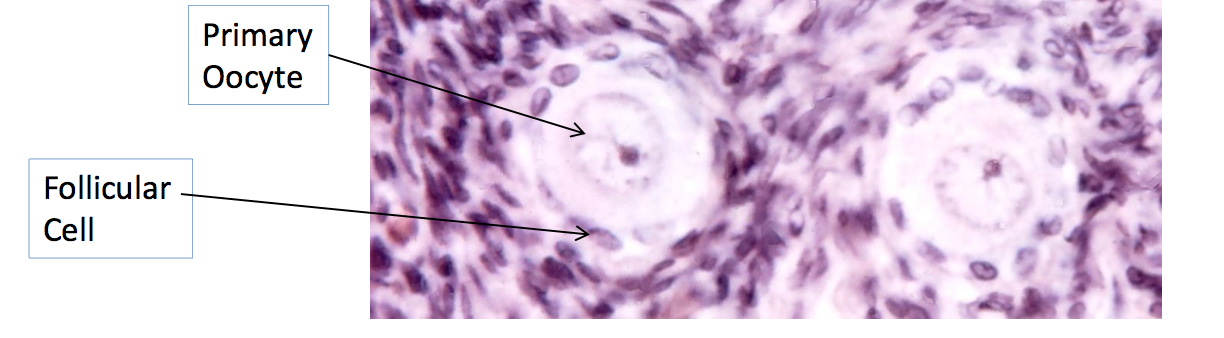

1
Q

A
ovary

2
Q

A
primoridal follicle
3
Q

A
4
Q

A
preantral follicle

5
Q

A
developing antral follicle

6
Q

A
antral follicle

7
Q

A
graffian follicle ready to ovulate

8
Q

A
corpus luteum

9
Q

A
corpus luteum
a= theca lutein cells b= granulosa lutein cells
10
Q

A
oviduct

11
Q

A
oviduct plica

12
Q

A
uterus

13
Q

A

14
Q

A
uterus in prolif phase

15
Q

A
uterus in secretory phase

16
Q

A
vagina

17
Q

A
inactive mammary gland

18
Q

A
proliferating mammary gland
CT= Connective Tissue A= adipose cell
L= lobule of glandular tissue
19
Q

A
lactating mammary gland
a=alveoli
d= duct
arrow= Ct septum
20
Q

A
testis
TA= tunica albugnisa

21
Q

A
parenchyma of testis

22
Q

A

23
Q

A
meadistinum testis w/ rete testis
24
Q

A
ductuli efferentes
25

ductuli epididymis
26

ductuli epididymis
(arrows= basal cells)
27

ductus deferens (vas deferens)
i= inner longitudinal
c= middle circular
o= outter longitudinal
28

seminal vesicles
29

prostate
30

prostate
31

prostate (at low mag)


